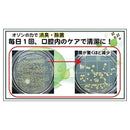
カモス オゾニールD ペット用 口臭口腔内お悩みケア 30ml

お支払い方法
商品詳細
主成分はオゾン化オリーブ油です。
オゾンの消臭・除菌力で、口腔内を清潔を保ち、歯石や口臭を予防します。
【使用方法】
1日に1回~2回程度、変色部分の被毛に本品を適量垂らし、よく塗り込んでください。
オゾンの消臭・除菌力で、口腔内を清潔を保ち、歯石や口臭を予防します。
【使用方法】
1日に1回~2回程度、変色部分の被毛に本品を適量垂らし、よく塗り込んでください。
使用上の注意
直射日光を避けなるべく涼しいところに保管してください。
キャップは必ず閉めてください。
お子様の手の届かないところに保管してください。
異常があらわれた場合は直ちに使用を止め、獣医師などにご相談ください。
オゾン化オリーブ油、オゾン化ヒマワリ種子油
30ml
株式会社カモス
TEL:03-6277-0886
株式会社カモス
日本
オゾニール
免責事項/広告文責
※※パッケージ・デザイン・内容等は、リニューアルにより予告なしに変更される場合がありますので、予めご了承ください。
※お届け地域によっては、表記されている日数よりもお届けにお時間を頂く場合がございます。
※ギフト包装は行っておりません。
※連続購入等の大量注文はキャンセルとさせていただく場合がございますので、予めご了承ください。
株式会社サンドラッグ/電話番号:0120‐009‐368
JAN
4582252173597